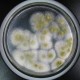
知名品牌菌落超48倍,菌落大全

大家好,今天小编关注到一个比较有意思的话题,就是关于中国代表连说5个反对的问题,于是小编就整理了5个相关介绍中国代表连说5个反对的解答,让我们一起看看吧。

5个四代表什么意思?
5个四代表“四位一体、四个全面”,是指“四位一体”即坚持以人民为中心的发展思想,坚持全面深化改革,坚持全面依法治国,坚持全面从严治党;“四个全面”即全面建设社会主义现代化国家、全面深化改革、全面依法治国、全面从严治党。
这一口号强调了中国目前的发展理念和目标,旨在全面推进现代化建设、深化改革开放、弘扬法治精神、坚决治理党风政风。
5个四代表五四运动。
五四运动是中国近现代史上的重要历史事件之一,也是中国民主学生运动的开端。
它发生在1919年5月4日,在北京的天安门广场上,主要表现为学生运动和反对帝国主义运动。
这个事件被认为是中国近代史上一次重要的转折点,代表着民族主义的崛起和现代化思想的兴起。
关于这个问题,这个短语通常用于描述一个家庭中有5个不同代数的人,如曾祖父、祖父、父亲、儿子和孙子。这表明这个家庭中有多个不同年龄和生活经历的人,代表着不同的价值观和文化传承。
中国古代重视读书反对劳动的的话?
中国古代也非常重视读书,如孔子曾说过“学而优而仕”,还有“劳心者治人,劳力者治于人”,俗语常说“书中自有黄金屋”,“万般脚下品,唯有读书高”,“书山有路勤为径,学海无涯苦作舟”,“书是人类进步的阶梯”,“读书是和高尚的人说话”,
顽固派的思想主张是什么?
以慈禧太后为头子的地主阶级顽固派——反动的封建专制势力的代表顽固派极力维护腐朽没落的封建专制制度,反对一切政治改革,仇视资本主义的文明,一方面,他们害怕外国势力促使封建社会解体和资本主义因素发展,因而盲目地排外;
另一方面又极其害怕国内人民的革命斗争,不惜出卖国家主权和民族利益,勾结帝国主义对之进行镇压,他们虽在垂死挣扎,却得到朝野上下一切反动的封建势力的支持,形成强大的同盟,牢牢地掌握着军政大权,
新中国成立后,我国奉行怎样的外交政策?新中国外交成熟的标志?
新中国外交政策成熟的标志是和平共处五项原则的提出。
和平共处五项原则”主张国家不分大小、社会制度异同,一律平等,和平共处。这使它成为国际关系的普遍准则。
和平共处五项原则之所以成为新中国外交政策成熟的标志,主要是因为它成为解决国与国之间问题的基本原则。
独立自主和平外交政策和“和平共处五项原则”。
新中国奉行独立自主的和平外交政策,它成为我国对外关系的基本出发点。这一政策以保障本国领土主权完整、维护国际的持久和平与各国人民的友好合作、反对帝国主义侵略政策为基本原则。
新中国建立之初,两大阵营处于对立和激烈斗争状态,再加上帝国主义国家对新中国采取外交孤立的政策,所以使得新中国独立自主外交政策的基本方针表现为“另起炉灶”、“打扫干净屋子再请客”和“一边倒”。随着“和平共处五项原则”的提出,中国的外交政策逐渐走向成熟。
新中国成立之初,我国奉行“一边倒”、“另起炉灶”、“打扫屋子再请客”的外交政策,明确表示我国与苏联社会主义一起反对帝国主义与霸权主义;不承认旧政府与外国签订的不平等条约;新中国愿与一切和平友好国家重新签订友好外交外交关系。1954年,我国提出“和平共处五项原则”标志着我国外交政策的成熟。
五星红旗的五颗星星代表什么?
五星红旗的五颗星星代表着中国共产党领导下的五个阶级:工人阶级、农民阶级、城市小资产阶级、民族资产阶级和知识分子。五颗星星的排列方式,从左到右依次为:大星、二星、三星、四星、小星,代表着中国各阶级在中国共产党领导下团结一致、共同奋斗,实现国家繁荣、人民幸福的愿景。五星红旗代表着中国人民的团结和力量,是中国共产党领导下的新中国的象征。同时,五星红旗也代表了中国人民在长期革命斗争中的坚定信仰和不屈精神。
到此,以上就是小编对于中国代表连说5个反对的问题就介绍到这了,希望介绍关于中国代表连说5个反对的5点解答对大家有用。